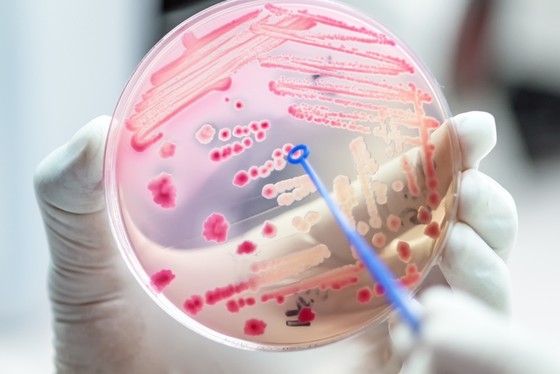
AMR plate

Cefas International aims to keep you informed of the breadth of marine and freshwater science work we carry out across the world on behalf of and in partnership with UK Government, other governments, academia, NGOs and business. Our research and advice help ensure that our oceans, seas and rivers are healthy and productive, providing food and valuable natural resources for the world’s population now and in the future.
This edition focuses on our work in the Middle East, we hope you find it informative. To subscribe for future editions please click here.
|
|
Second edition: Focus on the Middle East
|
|
|
 From left to right: Cefas’ Operations Director Steve Millward and the British Ambassador to Kuwait Michael Davenport.
Cefas officially opened its new office at the British Embassy in Kuwait on October 15th. In attendance was the in-country team of scientists, Cefas’ Operations Director Steve Millward, and the British Ambassador to Kuwait Michael Davenport.
Since 2014 Cefas has had a permanent presence at the Embassy, working with the Kuwait Environment Public Authority (KEPA) to assess the health of the seas surrounding Kuwait City. Cefas and KEPA hope to shortly start work on a significant new joint project to develop an extensive understanding of Kuwait’s marine environment, which will improve and energise both national and regional ocean governance to protect the Gulfs’ marine ecosystems. This will help sustain regional food and water security and support sustainable economic growth and diversification. Utilising marine expertise within Cefas, the project will promote international best practice and address prominent issues including those of marine litter pollution and the protection of critically endangered species and habitats that are located within the Gulf.
The British Ambassador in Kuwait said "the British Embassy warmly welcomes the expansion of the Cefas office in Kuwait, and we will continue to support Cefas as a key UK Government Agency, in providing technical assistance and support to our partners here in Kuwait. As a proud maritime nation, the UK, like Kuwait, shares a long cultural and historical association with the sea, and understands the importance of it for social and economic development."
UK-Gulf Marine Environment Partnership (UK-GMEP) Programme updates
 Fishing boat in Oman.
The UK-GMEP Programme
builds on Cefas’ long standing collaboration with the Gulf which spans four
decades, six countries, and two overseas offices.
Through the UK-GMEP Programme
Cefas is working with partner organisations in the Gulf to address the
challenges of marine environmental management by strengthening regulation,
developing the knowledge-base to inform management, and building capacity for
long-term sustainable management.
The programme focuses on five
key areas: food security, sustainable development, human health, climate
change, and marine conservation.
Investigating the role of the marine environment in the development and spread of antibiotic resistance
Bacterial cultures being prepared in a laboratory prior to resistance screening.
It’s one of the biggest threats to
global health, food security and development, and can affect anyone, of any
age, in any country. But what role do our oceans play in the rising issue of
antibiotic resistance?
The marine environment is a reservoir
for antibiotic resistant bacteria, transported into our oceans through sewage,
aquaculture discharge and agricultural runoff. But our oceans don't just harbour
resistant bacteria, they may also enable its spread and development.
Cefas is working with partners across
the Gulf, including King Saud bin Abdulaziz University Saudi Arabia, to improve
our understanding of the role of Gulf in the development and spread of
antibiotic resistance, otherwise known as antimicrobial resistance or AMR. A recent review by Cefas and partners identified that specific demographic and environmental factors make the Gulf a
potential hotspot for the propagation and development of AMR.
Following on from this the team are
preparing for an internationally coordinated survey of AMR in waters of the
Gulf Cooperation Council countries of the Arabian Gulf, with the first water
samples due to be collected by the end of the month. In addition to providing
further information on the extent of AMR in the Gulf this study is one of the
first attempts to conduct an internationally coordinated marine AMR sampling
programme, which will provide valuable lessons for future studies.
Securing a brighter future for Oman’s fisheries and aquaculture industries
 Cefas' Chris Evans providing training to Oman Ministry of Agriculture and Fisheries staff on sample collection and preparation for disease diagnostics.
Fisheries and aquaculture not only
provide an important source of food, but they play a vital role in economic
diversification and job creation. This has been recognised by the government of
Oman who have identified fisheries and aquaculture as one of the five main
pillars for national economic diversification. Effective and informed management
is essential to sustainably develop this sector whilst avoiding the pitfalls of
overfishing and aquatic disease.
Cefas helped the Oman Ministry of
Agriculture and Fisheries (MAF) introduce fisheries management and aquaculture
health management development programmes into the national economic
diversification strategy. The ongoing collaboration is now working on the
implementation of these programmes. Over the last year Cefas has worked with
MAF to draft a revision to aquaculture bylaw, established a revised aquaculture
disease surveillance programme, and provided training to MAF staff in aquatic
disease diagnosis in both the UK and Oman.
In the coming months the collaboration
will broaden to consider fisheries management. Cefas staff will support the MAF
to develop a sustainable management programme for the experimental horse
mackerel fishery, a new pelagic fishery that Oman is seeking to establish in
the northern Arabian Sea.
The Gulf marine environment prepares for the consequences of climate change
 Map of global chlorophyll levels.
Climate change will affect every
ecosystem on the planet and will have a significant impact on the marine
environment, the life it supports, and the role it plays in our lives. To minimise and mitigate the effects of
climate change Cefas’ centre of Excellence in Marine Climate Change are working
with Gulf experts to explore the consequences of climate change, both today and
in years to come.
Cefas is working with ROPME, the
Regional Organisation for the Protection of the Marine Environment, on issues
related to marine climate change across the 8 countries that border the Gulf.
This work will provide the ROPME member states with the evidence base and tools
to prepare for the challenges of climate change that lie ahead, minimising the
harm to the marine environment.
Cefas is currently preparing a rapid regional marine climate change
impact assessment for ROPME area and are looking forward to discussing a shared
lessons and concerns with the 8 ROPME member states during a regional marine
climate change meeting in November.
Thank you for reading. Our next edition of Cefas International News will focus on South East Asia, to subscribe to future editions click here.
|